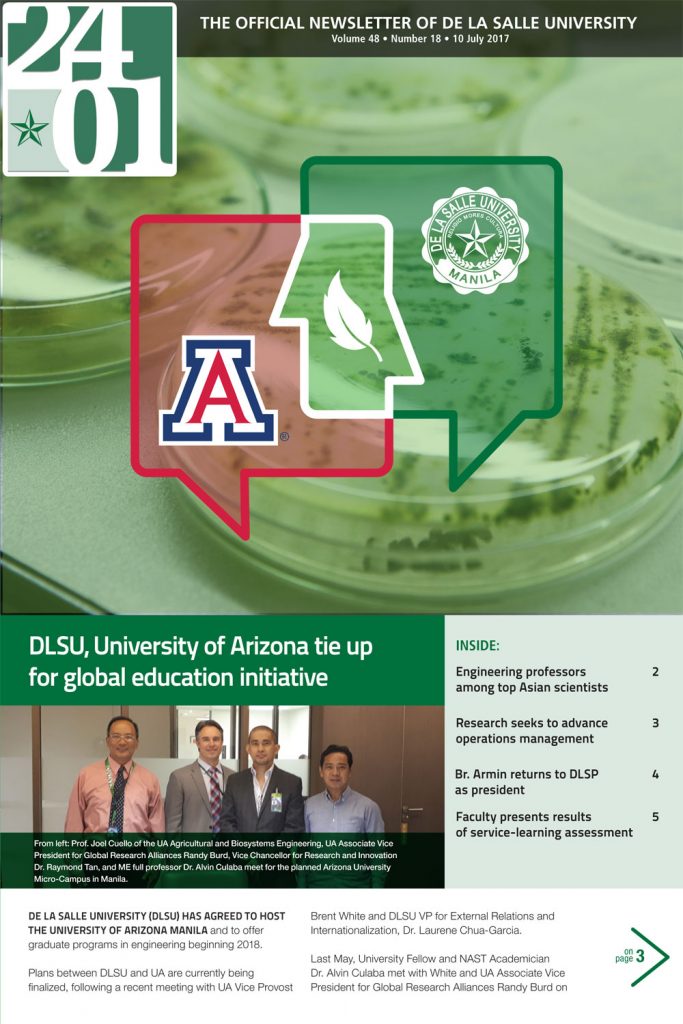

2401 - The Official Newsletter of De La Salle University
2401 (twen’të fôr’, ö, wun) is a landmark along Taft Avenue. It is the location ID of De La Salle University-Manila, home to outstanding faculty and students, and birthplace of luminaries in business, public service, education, the arts, and science. And 2401 is now the new name of the official newsletter of DLSU-Manila, featuring developments and stories of interest about the university.
Vol. 57 No.06 12/12/2025 (pdf/5.55Mb)
Vol. 57 No.04 11/28/2025 (pdf/12.0Mb)
Vol. 57 No.04 11/05/2025 (pdf/5.86Mb)
Vol. 57 No.03 10/15/2025 (pdf/1.24Mb)
Vol. 57 No.02 09/26/2025 (pdf/9.92Mb)
Vol. 57 No.01 09/12/2025 (pdf/7.23Mb)
Vol. 56 No.19 08/25/2025 (pdf/3.61Mb)
Vol. 56 No.18 08/05/2025 (pdf/6.79Mb)
Vol. 56 No.17 07/25/2025 (pdf/11.0Mb)
Vol. 56 No.16 07/09/2025 (pdf/8.51Mb)
Vol. 56 No.15 06/20/2025 (pdf/29.3Mb)
Vol. 56 No.14 06/05/2025 (pdf/10Mb)
Vol. 56 No.13 05/16/2025 (pdf/8.2Mb)
Vol. 56 No.12 04/25/2025 (pdf/7.7Mb)
Vol. 56 No.11 04/02/2025 (pdf/7.35Mb)
Vol. 56 No.10 03/17/2025 (pdf/26.8Mb)
Vol. 56 No.09 03/03/2025 (pdf/4.59Mb)
Vol. 56 No.08 02/19/2025 (pdf/3.27Mb)
Vol. 56 No.07 01/31/2025 (pdf/2.25Mb)
Vol. 56 No.06 01/15/2025 (pdf/6.28Mb)
Vol. 56 No.05 12/09/2024 (pdf/12.7Mb)
Vol. 56 No.04 11/19/2024 (pdf/5.31Mb)
Vol. 56 No.03 10/28/2024 (pdf/3.85Mb)
Vol. 56 No.02 10/09/2024 (pdf/6.16Mb)
Vol. 56 No.01 09/25/2024 (pdf/5.65Mb)
Vol. 55 No.19 09/02/2024 (pdf/22.3Mb)
Vol. 55 No.18 08/14/2024 (pdf/7.29Mb)
Vol. 55 No.17 07/29/2024 (pdf/3.31Mb)
Vol. 55 No.16 07/05/2024 (pdf/8.17Mb)
Vol. 55 No.15 06/21/2024 (pdf/8.31Mb)
Vol. 55 No.14 05/24/2024 (pdf/14.6Mb)
Vol. 55 No.12 04/12/2024 (pdf/8.13Mb)
Vol. 55 No.11 03/20/2024 (pdf/6.47Mb)
Vol. 55 No.10 02/28/2024 (pdf/6.88Mb)
Vol. 55 No.09 02/14/2024 (pdf/6.61Mb)
Vol. 55 No.08 01/29/2024 (pdf/5.07Mb)
Vol. 55 No.07 01/12/2024 (pdf/10.4Mb)
Vol. 55 No.06 12/07/2023 (pdf/9.15Mb)
Vol. 55 No.05 11/22/2023 (pdf/7.68Mb)
Vol. 55 No.04 11/10/2023 (pdf/7.34Mb)
Vol. 55 No.03 10/09/2023 (pdf/12.5Mb)
Vol. 55 No.02 09/25/2023 (pdf/17.0Mb)
Vol. 55 No.01 09/11/2023 (pdf/12.5Mb)
Vol. 54 No.18, 08/23/2023 (pdf/6.70Mb)
Vol. 54 No.17 08/07/2023 (pdf/13.3Mb)
Vol. 54 No.17 Special, 08/07/2023 (pdf/3.62Mb)
Vol. 54 No.16, 07/17/2023 (pdf/18.7Mb)
Vol. 54 No.15, 07/05/2023 (pdf/15.5Mb)
Vol. 54 No.14, 06/13/2023 (pdf/4.82Mb)
Vol. 54 No.13, 05/26/2023 (pdf/3.62Mb)
Vol. 54 No.12, 05/05/2023 (pdf/7.73Mb)
Vol. 54 No.11, 04/17/2023 (pdf/10.9Mb)
Vol. 54 No.10, 03/27/2023 (pdf/13.4Mb)
Vol. 54 No.09, 03/13/2023 (pdf/7.02Mb)
Vol. 54 No.08, 02/20/2023 (pdf/7.02Mb)
Vol. 54 No.07, 02/03/2023 (pdf/11.5Mb)
Vol. 54 No.06, 01/16/2023 (pdf/6.88Mb)
Vol. 54 No.05, 12/05/2022 (pdf/10.7Mb)
Vol. 54 No.04, 11/21/2022 (pdf/13.2Mb)
Vol. 54 No.03, 11/04/2022 (pdf/3.52Kb)
Vol. 54 No.02, 10/17/2022 (pdf/4.16Mb)
Vol. 54 No.01, 09/23/2022 (pdf/19.5Kb)
Vol. 53 No.16, 08/31/2022 (pdf/1.99Mb)
Vol. 53 No.15, 08/10/2022 (pdf/8.69Mb)
Vol. 53 No.14, 07/25/2022 (pdf/10.2Mb)
Vol. 53 No.13, 07/12/2022 (pdf/6.9Mb)
Vol. 53 No.12, 06/06/2022 (pdf/2.17Mb)
Vol. 53 No.11, 05/23/2022 (pdf/4.98Mb)
Vol. 53 No.11 Br. Armin 05/25/2022 (pdf/5.55Mb)
Vol. 53 No.10 04/29/2022 (pdf/2.80Mb)
Vol. 53 No.09, 04/09/2022 (pdf/636Kb)
Vol. 53 No.08 03/21/2022 (pdf/13.5Mb)
Vol. 53 No.07, 03/07/2022 (pdf/4.40Mb)
Vol. 53 No.06 02/14/2022 (pdf/6.83Mb)
Vol. 53 No. 05, 01/28/2022 (pdf/7.82Mb)
Vol. 53 No.04, 12/14/2021 (pdf/9.64Mb)
Vol. 53 No. 03, 11/26/2021 (pdf/1.14Mb)
Vol. 53 No.02, 11/05/2021 (pdf/6.98Mb)
Vol. 53 No. 01, 10/18/2021 (pdf/7.28Mb)
Vol. 52 No.19, 09/27/2021 (pdf/2.89Mb)
Vol. 52 No.18, 09/13/2021 (pdf/7.43Mb)
Vol. 52 No.17, 08/23/2021 (pdf/0.98Mb)
Vol. 52 No.16, 08/02/2021 (pdf/5.12Mb)
Vol. 52 No.15, 07/15/2021 (pdf/2.20Mb)
Vol. 52 No.14, 06/14/2021 (pdf/16.7Mb)
Vol. 52 No.13, 04/24/2021 (pdf/997Kb)
Vol. 52 No.12, 05/10/2021 (pdf/1.57Mb)
Vol. 52 No.11, 04/26/2021 (pdf/6.88Mb)
Vol. 52 No.10, 04/12/2021 (pdf/2.74Mb)
Vol. 52 No.09, 03/22/2021 (pdf/4.84Mb)
Vol. 52 No.08, 03/08/2021 (pdf/793Kb)
Vol. 52 No.07, 02/15/2021 (pdf/2.62Mb)
Vol. 52 No.06, 01/29/2021 (pdf/12.5Mb)
Vol. 52 No.05, 01/15/2021 (pdf/4.95Mb)
Vol. 52 No.04, 12/15/2020 (pdf/8.75Mb)
Vol. 52 No.03, 11/25/2020 (pdf/3.53Mb)
Vol. 52 No.02, 11/09/2020 (pdf/3.22Mb)
Vol. 52 No.01, 10/27/2020 (pdf/6.79Mb)
Vol. 51 No.20, 09/28/2020 (pdf/2.57Mb)
Vol. 51 No.19, 09/14/2020 (pdf/10.0Mb)
Vol. 51 No.18, 08/31/2020 (pdf/1.52Mb)
Vol. 51 No.17, 08/17/2020 (pdf/10.6Mb)
Vol. 51 No.16, 07/31/2020 (pdf/6.47 Mb)
Vol. 51 No.15, 07/20/2020 (pdf/5.72 Mb)
Vol. 51 No.14 tribute, 06/27/2020 (pdf/1.70 Mb)
Vol. 51 No.14, 06/27/2020 (pdf/3.91 Mb)
Vol. 51 No.13, 05/19/2020 (pdf/4.59 Mb)
Vol. 51 No.12, 04/25/2020 (pdf/9.01 Mb)
Vol. 51 No.11, 03/20/2020 (pdf/2.26 Mb)
Vol. 51 No.10, 03/02/2020 (pdf/6.84 Mb)
Vol. 51 No.09, 02/17/2020 (pdf/5.77 Mb)
Vol. 51 No.08, 02/03/2020 (pdf/13.0 Mb)
Vol. 51 No.07, 01/22/2020 (pdf/11.02 Mb)
Vol. 51 No.06, 12/16/2019 (pdf/8.37Mb)
Vol. 51 No.05, 11/25/2019 (pdf/2.63 Mb)
Vol. 51 No.04, 11/11/2019 (pdf/15.2 Mb)
Vol. 51 No.03, 10/21/2019 (pdf/3.78 Mb)
Vol. 51 No.02, 10/07/2019 (pdf/39.1 Mb)
Vol. 51 No.01, 00/00/2019 (pdf/0.00 Kb)
Vol. 50 No.20, 09/09/2019 (pdf/547 Kb)
Vol. 50 No.19, 08/12/2019 (pdf/8.67 Mb)
Vol. 49 No.4, 10/23/2017 (pdf/3.96Mb)
Vol. 49 No. 7, 01/08/2018 (pdf/8.55Mb)
Vol. 48 No. 19, 07/24/2017(pdf/4.44Mb)
Vol. 48 No. 19 Field Notes, 07/24/2017(pdf/17.9Mb)
Vol. 48 No. 17, 06/27/2017(pdf/2.51Mb)
Vol. 48 No. 18, 07/10/2017(pdf/5.92Mb)
Vol. 48 No. 15, 05/29/2017(pdf/6.27Mb)
Vol. 48 No. 16, 06/13/2017(pdf/15.3Mb)
Vol. 48 No. 12, 03/27/2017(pdf/4.44Mb)
Vol. 48 No. 13, 04/10/2017(pdf/11.1Mb)
Vol. 48 No. 11, 03/13/2017(pdf/4.90Mb)
Vol. 48 No. 12 Field Notes, 03/27/2017(pdf/18.3Mb)
Vol. 48 No. 09, 02/13/2017(pdf/6.29Mb)
Vol. 48 No. 10, 02/27//2017(pdf/4.9Mb)
Vol. 48 No. 07, 01/16/2017(pdf/5.67Mb)
Vol. 48 No. 08, 01/30/2017(pdf/5.42Mb)
Archives
Vol. 48 No. 06, 12/12/2016(pdf/5.05Mb)
Vol. 48 No. 04 Field Notes, 11/03/2016(pdf/19.4Mb)
Vol. 48 No. 05, 11/21//2016(pdf/5.10Mb)
Vol. 48 No. 03, 10/17/2016(pdf/11.9Mb)
Vol. 48 No. 04, 11/03/2016(pdf/13.1Mb)
Vol. 48 No. 01, 09/19/2016(pdf/4.07Mb)
Vol. 48 No. 02, 10/03/2016(pdf/26.7Mb)
Archives
Special Term No. 01, 05/25/2015(pdf/5.89Mb)
Vol. 46 No. 19, 03/23/2015(pdf/3.96Mb)
Vol. 46 No. 20, 04/08/2015(pdf/3.20Mb)
Vol. 46 No. 17, 02/23/2015(pdf/4.26Mb)
Vol. 46 No. 18, 03/09/2015(pdf/6.29Mb)
Vol. 46 No. 15, 01/26/2015(pdf/5.47Mb)
Vol. 46 No. 16, 02/09/2015(pdf/4.46Mb)
Archives
Vol. 46 No. 13, 12/01/2014(pdf/6.5Mb)
Vol. 46 No. 12, 11/17/2014(pdf/5.75Mb)
Vol. 46 No. 11, 11/03/2014(pdf/6.85Mb)
Vol. 46 No. 12, 11/17/2014(pdf/4.02Mb)
Vol. 46 No. 09, 10/07/2014(pdf/0.99Mb)
Vol. 46 No. 10, 10/20/2014(pdf/1.0Mb)
Vol. 46 No. 07, 09/08/2014(pdf/6.66Mb)
Vol. 46 No. 08, 09/22/2014(pdf/0.99Mb)
Vol. 46 No. 05, 08/11/2014(pdf/7.19Mb)
Vol. 46 No. 06, 08/22/2014(pdf/13.5Mb)
Vol. 46 No. 03, 07/07/2014(pdf/5.98Mb)
Vol. 46 No. 04, 07/27/2014(pdf/11.4Mb)
Vol. 46 No. 01, 06/09/2014(pdf/2.41Mb)
Vol. 46 No. 02, 06/23/2014(pdf/4.02Mb)
Archives
Under construction
Archives
Under construction
Vol. 57 No.08 12/13/2026 (pdf/4.25Mb)
Vol. 57 No.07 01/23/2026 (pdf/17.7Mb)
- Vol. 43 No. 04, 07/18/2011(pdf/12.8Mb)
- Vol. 43 No. 03, 07/04/2011(pdf/18Mb)
- Vol. 43 No. 02, 05/31/2011
- Vol. 42 No. 21, 04/11/2011
- Vol. 42 No. 20, 03/28/2011
- Vol. 42 No. 19, 03/15/2011
- Vol. 42 No. 18, 02/28/2011
- Vol. 42 No. 17, 02/14/2011
- Vol. 42 No. 16, 01/31/2011
- Vol. 42 No. 15, 01/17/2011
- Vol. 42 No. 14, 12/13/2010 (pdf/617Kb)
- Vol. 42 No. 13, 11/22/2010 (pdf/660Kb)
- Vol. 42 No. 12, 11/08/2010 (pdf/665Kb)
- Vol. 42 No. 11, 10/26/2010 (pdf/573Kb)
- Insert (On the Lasallian Faith, Services, and Community) (pdf/1,462kb)
- Vol. 42 No. 10, 10/11/2010 (pdf/555Kb)
- Insert (Forging New Adventures) (pdf/1,241kb)
- Vol. 42 No. 09, 09/27/2010 (pdf/639Kb)
- Vol. 42 No. 08, 09/13/2010 (pdf/13.4Mb)
- Vol. 42 Special Edition, 08/31/2010 (pdf/1.14Mb)
- Vol. 42 No. 06, 08/16/2010 (pdf/732Kb)
- Vol. 42 No. 05, 08/02/2010 (pdf/515Kb)
- Vol. 42 No. 04, 07/19/2010 (pdf/692Kb)
- Vol. 42 Special Edition, 07/12/2010 (pdf/674Kb)
- Vol. 42 No. 03, 06/08/2010 (pdf/576Kb)
- Vol. 42 No. 02, 06/25/2010 (pdf/1.0Mb)
- Vol. 42 No. 01, 06/08/2010 (pdf/760Kb)
- Vol. 41 No. 21, 04/14/2010 (pdf/1.20Mb)
- Vol. 41 No. 20, 03/29/2010 (pdf/1.07Mb)
- Vol. 41 No. 19, 03/15/2010 (pdf/1.16Mb)
- Vol. 41 No. 18, 03/01/2010 (pdf/1.71Mb)
- Vol. 41 No. 17, 02/15/2010 (pdf/1.04Mb)
- Vol. 41 No. 16, 02/01/2010 (pdf/1.20Mb)
- Vol. 41 No. 15, 01/18/2010 (pdf/1.10Mb)
- Vol. 41 No. 14, 12/14/2009 (pdf/1.20Mb)
- Vol. 41 No. 13, 12/01/2009 (pdf/1.03Mb)
- Vol. 41 No. 12, 11/16/2009 (pdf/1.00Mb)
- Vol. 41 No. 11, 11/03/2009 (pdf/1.00Mb)
- Vol. 41 No. 10, 10/19/2009 (pdf/926kb)
- Vol. 41 No. 09, 10/05/2009 (pdf/1.09Mb)
- Vol. 41 No. 08, 09/21/2009 (pdf/1.13Mb)
- Vol. 41 No. 07, 09/07/2009 (pdf/1.74Mb)
- Vol. 41 No. 06, 08/24/2009 (pdf/1.10Mb)
- Vol. 41 No. 05, 08/10/2009 (pdf/1.38Mb)
- Vol. 41 No. 04, 07/27/2009 (pdf/1.37Mb)
- Vol. 41 No. 03, 07/13/2009 (pdf/1.47Mb)
- Vol. 41 No. 02, 06/29/2009 (pdf/1.07Mb)
- Vol. 41 No. 01, 06/01/2009 (pdf/1.16Mb)
- Vol. 40 No. 21, 04/13/2009 (pdf/1.14Mb)
- Vol. 40 No. 20, 03/23/2009 (pdf/3.97Mb)
- Vol. 40 No. 19, 03/09/2009 (pdf/1.37Mb)
- Vol. 40 No. 18, 02/24/2009 (pdf/1.51Mb)
- Vol. 40 No. 17, 02/09/2009 (pdf/1.39Mb)
- Vol. 40 No. 16, 01/26/2009 (pdf/1.64Mb)
- Vol. 40 No. 15, 01/12/2009 (pdf/1.72Mb)
- Vol. 40 No. 14, 12/09/2008 (pdf/1.02Mb)
- Vol. 40 No. 13, 11/24/2008 (pdf/1.44Mb)
- Vol. 40 No. 12, 11/10/2008 (pdf/4.78Mb)
- Vol. 40 No. 11, 10/24/2008 (pdf/1.14Mb)
- Vol. 40 No. 10, 10/06/2008 (pdf/872kb)
- Vol. 40 No. 09, 09/22/2008 (pdf/1.11Mb)
- Vol. 40 No. 08, 09/08/2008 (pdf/781kb)
- Vol. 40 No. 07, 08/25/2008 (pdf/1.05Mb)
- Vol. 40 No. 06, 08/11/2008 (pdf/862kb)
- Vol. 40 No. 05, 07/28/2008 (pdf/960kb)
- Vol. 40 No. 04, 07/14/2008 (pdf/858kb)
- Vol. 40 No. 03, 06/30/2008 (pdf/886kb)
- Vol. 40 No. 02, 06/16/2008 (pdf/1Mb)
- Vol. 40 No. 01, 06/02/2008 (pdf/842kb)
- Vol. 39 No. 21, 04/07/2008 (pdf/891kb)
- Vol. 39 No. 20, 03/24/2008 (pdf/807kb)
- Vol. 39 No. 19, 03/10/2008 (pdf/766kb)
- Vol. 39 No. 18, 02/25/2008 (pdf/470kb)
- Vol. 39 No. 17, 02/11/2008 (pdf/333kb)
- Vol. 39 No. 16, 01/28/2008 (pdf/250kb)
- Vol. 39 No. 15, 01/14/2008 (pdf/772kb)
- Vol. 39 No. 14, 12/10/2007 (pdf/441kb)
- Vol. 39 No. 13, 11/26/2007 (pdf/708kb)
- Vol. 39 No. 12, 11/12/2007 (pdf/582kb)
- Vol. 39 No. 11, 10/22/2007 (pdf/837kb)
- Vol. 39 No. 10, 10/08/2007 (pdf/548kb)
- Vol. 39 No. 09, 09/24/2007 (pdf/379kb)
- Vol. 39 No. 08, 09/10/2007 (pdf/1.86Mb)
- Vol. 39 No. 07, 08/23/2007 (pdf/1.62Mb)
- Vol. 39 No. 06, 08/06/2007 (pdf/394kb)
- Vol. 39 No. 05, 07/23/2007 (pdf/277kb)
- Vol. 39 No. 04, 07/09/2007 (pdf/367kb)
- Vol. 39 No. 03, 06/25/2007 (pdf/753kb)
- Vol. 39 No. 02, 06/11/2007 (pdf/517kb)
- Vol. 39 No. 01, 05/28/2007 (pdf/461kb)
- Vol. 38 No. 22, 04/02/2007 (pdf/427kb)
- Vol. 38 No. 21, 03/19/2007 (pdf/397kb)
- Vol. 38 No. 20, 03/05/2007 (pdf/301kb)
- Vol. 38 No. 19, 02/21/2007 (pdf/391kb)
- Vol. 38 No. 18, 02/05/2007 (pdf/429kb)
- Vol. 38 No. 17, 01/22/2007 (pdf/381kb)
- Vol. 38 No. 16, 01/08/2007 (pdf/584kb)
- Vol. 38 No. 15, 12/04/2006 (pdf/332kb)
- Vol. 38 No. 14, 11/20/2006 (pdf/521kb)
- Vol. 38 No. 13, 11/06/2006 (pdf/378kb)
- Vol. 38 No. 12, 10/23/2006 (pdf/411kb)
- Vol. 38 No. 11, 10/09/2006 (pdf/363kb)
- Vol. 38 No. 10, 09/25/2006 (pdf/326kb)
- Vol. 38 No. 09, 09/11/2006 (pdf/445kb)
- Vol. 38 No. 08, 08/28/2006 (pdf/377kb)
- Vol. 38 No. 07, 08/14/2006 (pdf/372kb)
- Vol. 38 No. 06, 07/31/2006 (pdf/980kb)
- Vol. 38 No. 05, 07/17/2006 (pdf/461kb)
- Vol. 38 No. 04, 07/03/2006 (pdf/1.09Mb)
- Vol. 38 No. 03, 06/19/2006 (pdf/1.02Mb)
- Vol. 38 No. 02, 06/05/2006 (pdf/457kb)
- Vol. 38 No. 01, 05/22/2006 (pdf/282kb)
- Vol. 37 No. 30, 04/03/2006 (pdf/413kb)
- Vol. 37 No. 29, 03/20/2006 (pdf/196kb)
- Vol. 37 No. 28, 03/06/2006 (pdf/271kb)
- Vol. 37 No. 27, 02/20/2006 (pdf/428kb)
- Vol. 37 No. 26, 02/06/2006 (pdf/733kb)
- Vol. 37 No. 25, 01/23/2006 (pdf/524kb)
- Vol. 37 No. 24, 01/09/2006 (pdf/371kb)
- Vol. 37 No. 23, 12/19/2005 (pdf/457kb)
- Vol. 37 No. 22, 12/05/2005 (pdf/304kb)
- Vol. 37 No. 21, 11/21/2005 (pdf/267kb)
- Vol. 37 No. 20, 11/07/2005 (pdf/242kb)
- Vol. 37 No. 19, 10/17/2005 (pdf/324kb)
- Vol. 37 No. 18, 10/03/2005 (pdf/414kb)
- Vol. 37 No. 17, 09/19/2005 (pdf/469kb)
- UNDER CONSTRUCTION